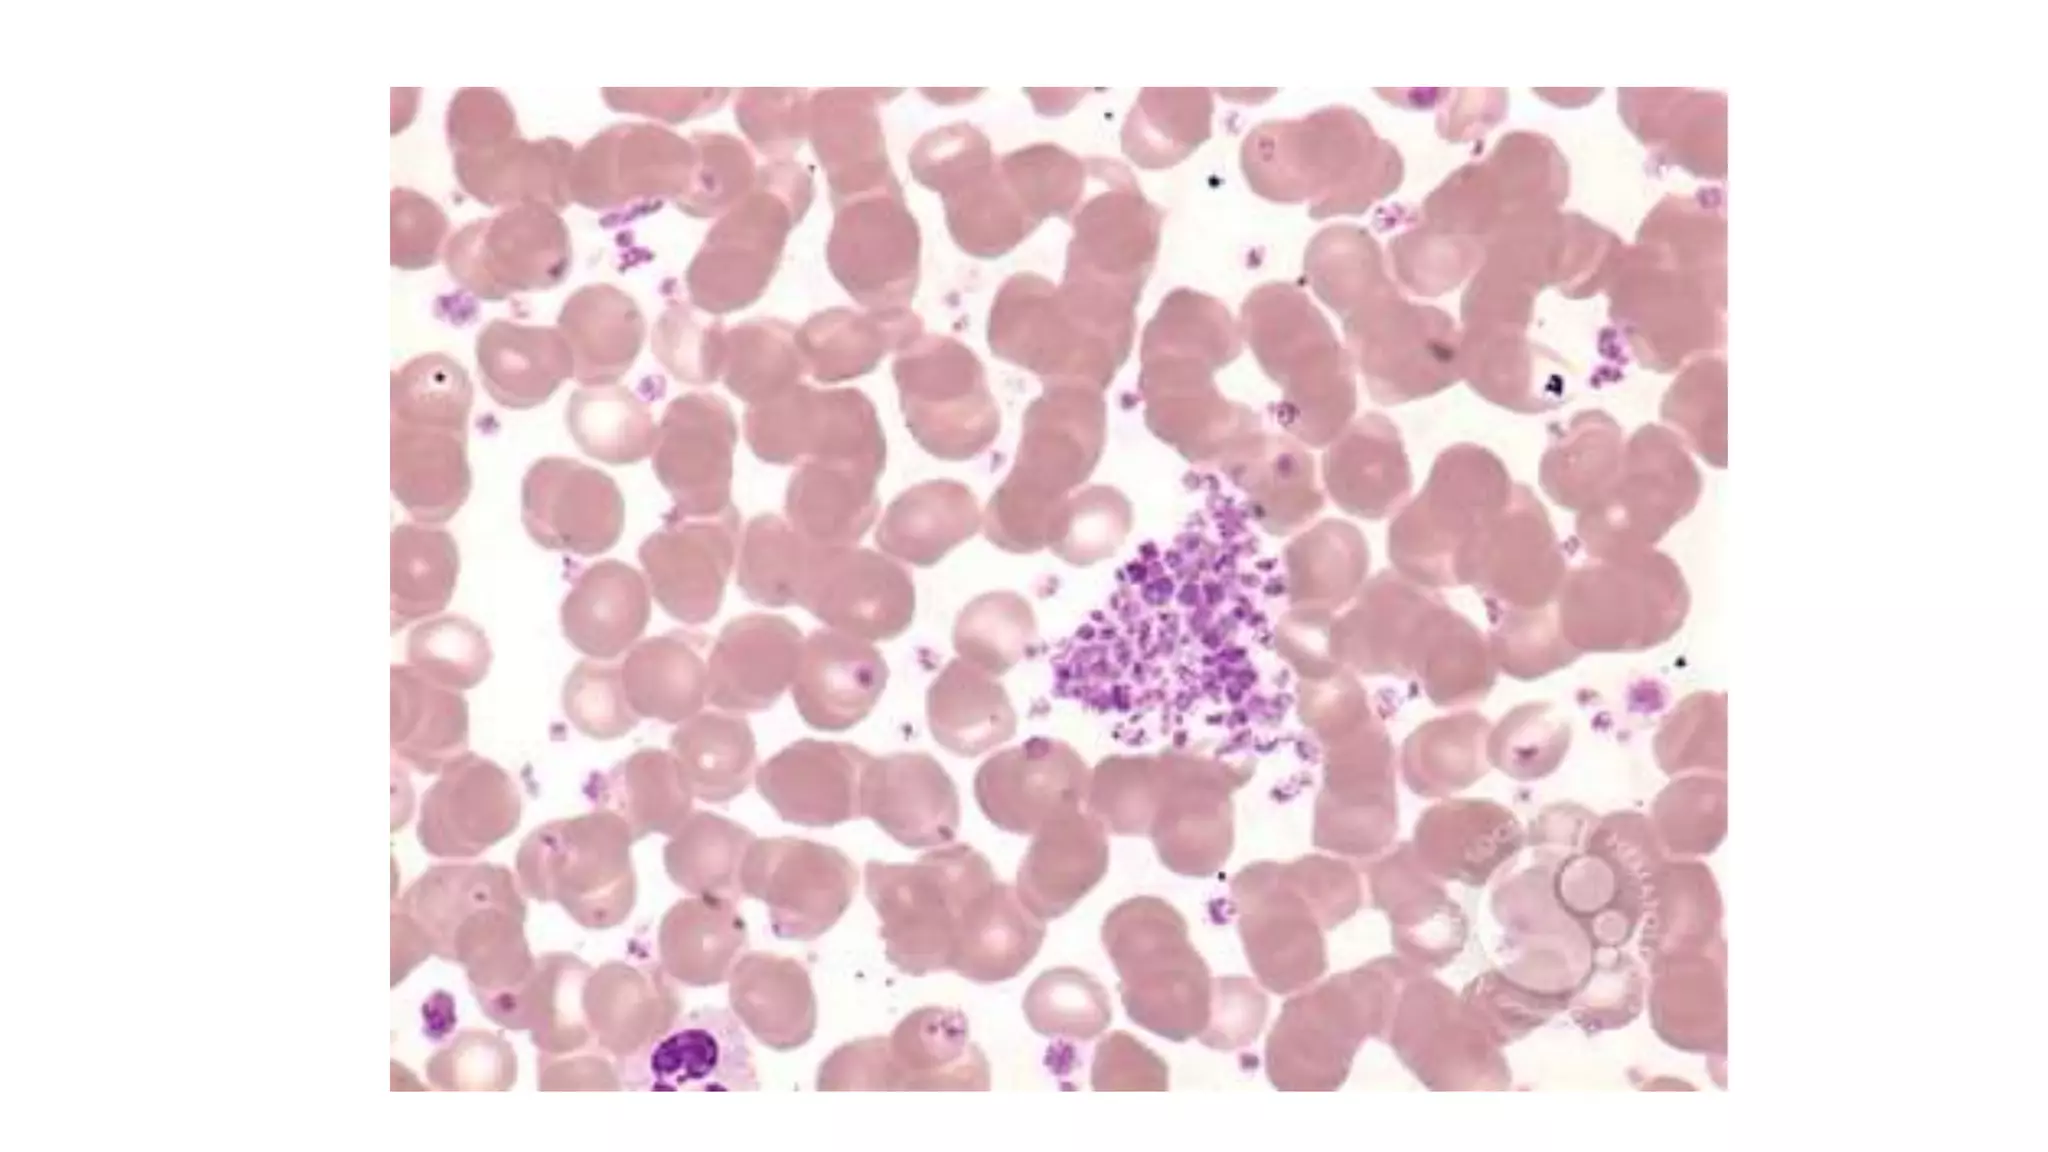
Myeloid neoplasm . Dr. Abhinav Golla , Associate Professor , Lab Director & Consultant Pathologist . Aadhya Medicure Pathlabs .
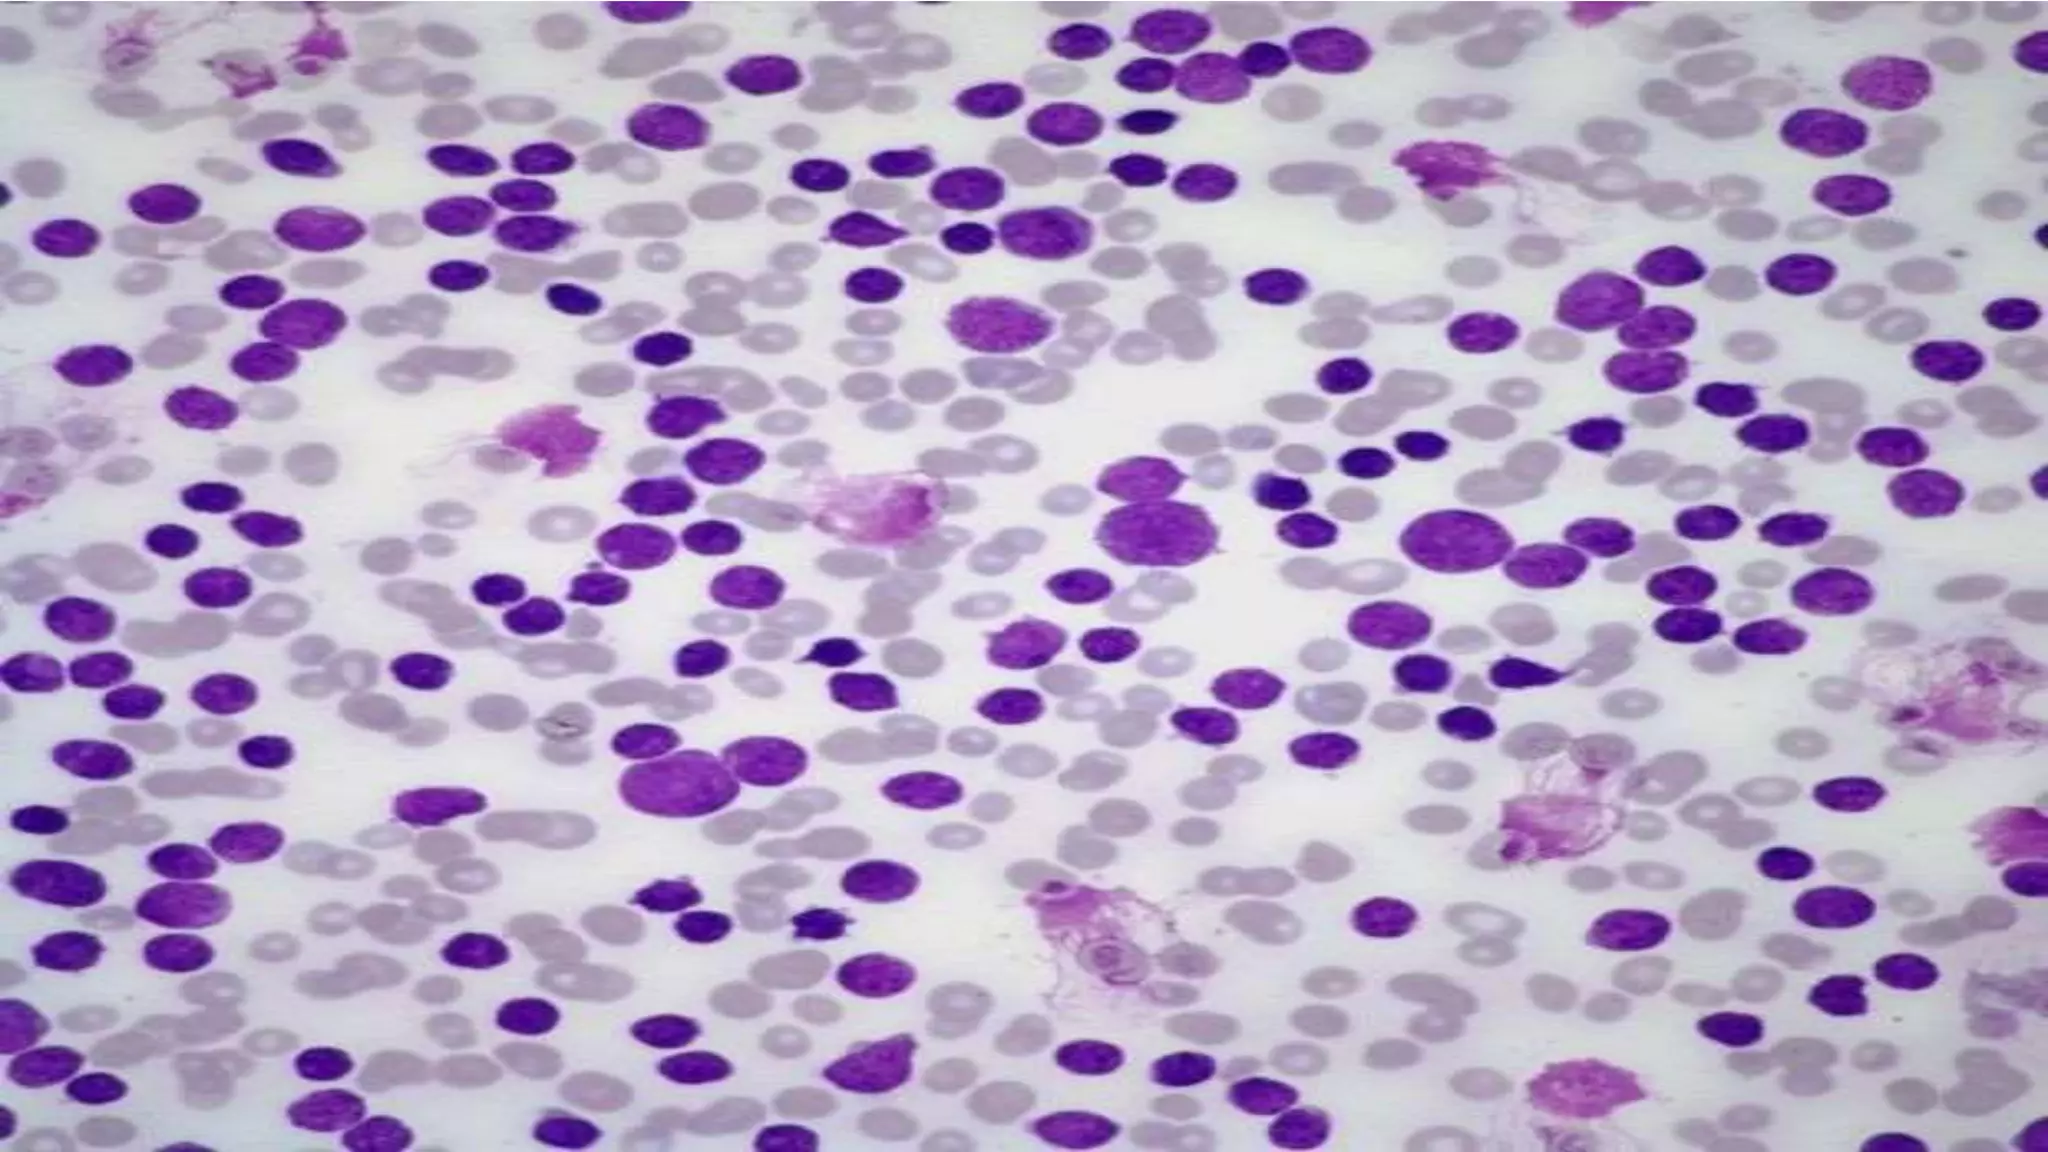
Myeloid neoplasm . Dr. Abhinav Golla , Associate Professor , Lab Director & Consultant Pathologist . Aadhya Medicure Pathlabs .
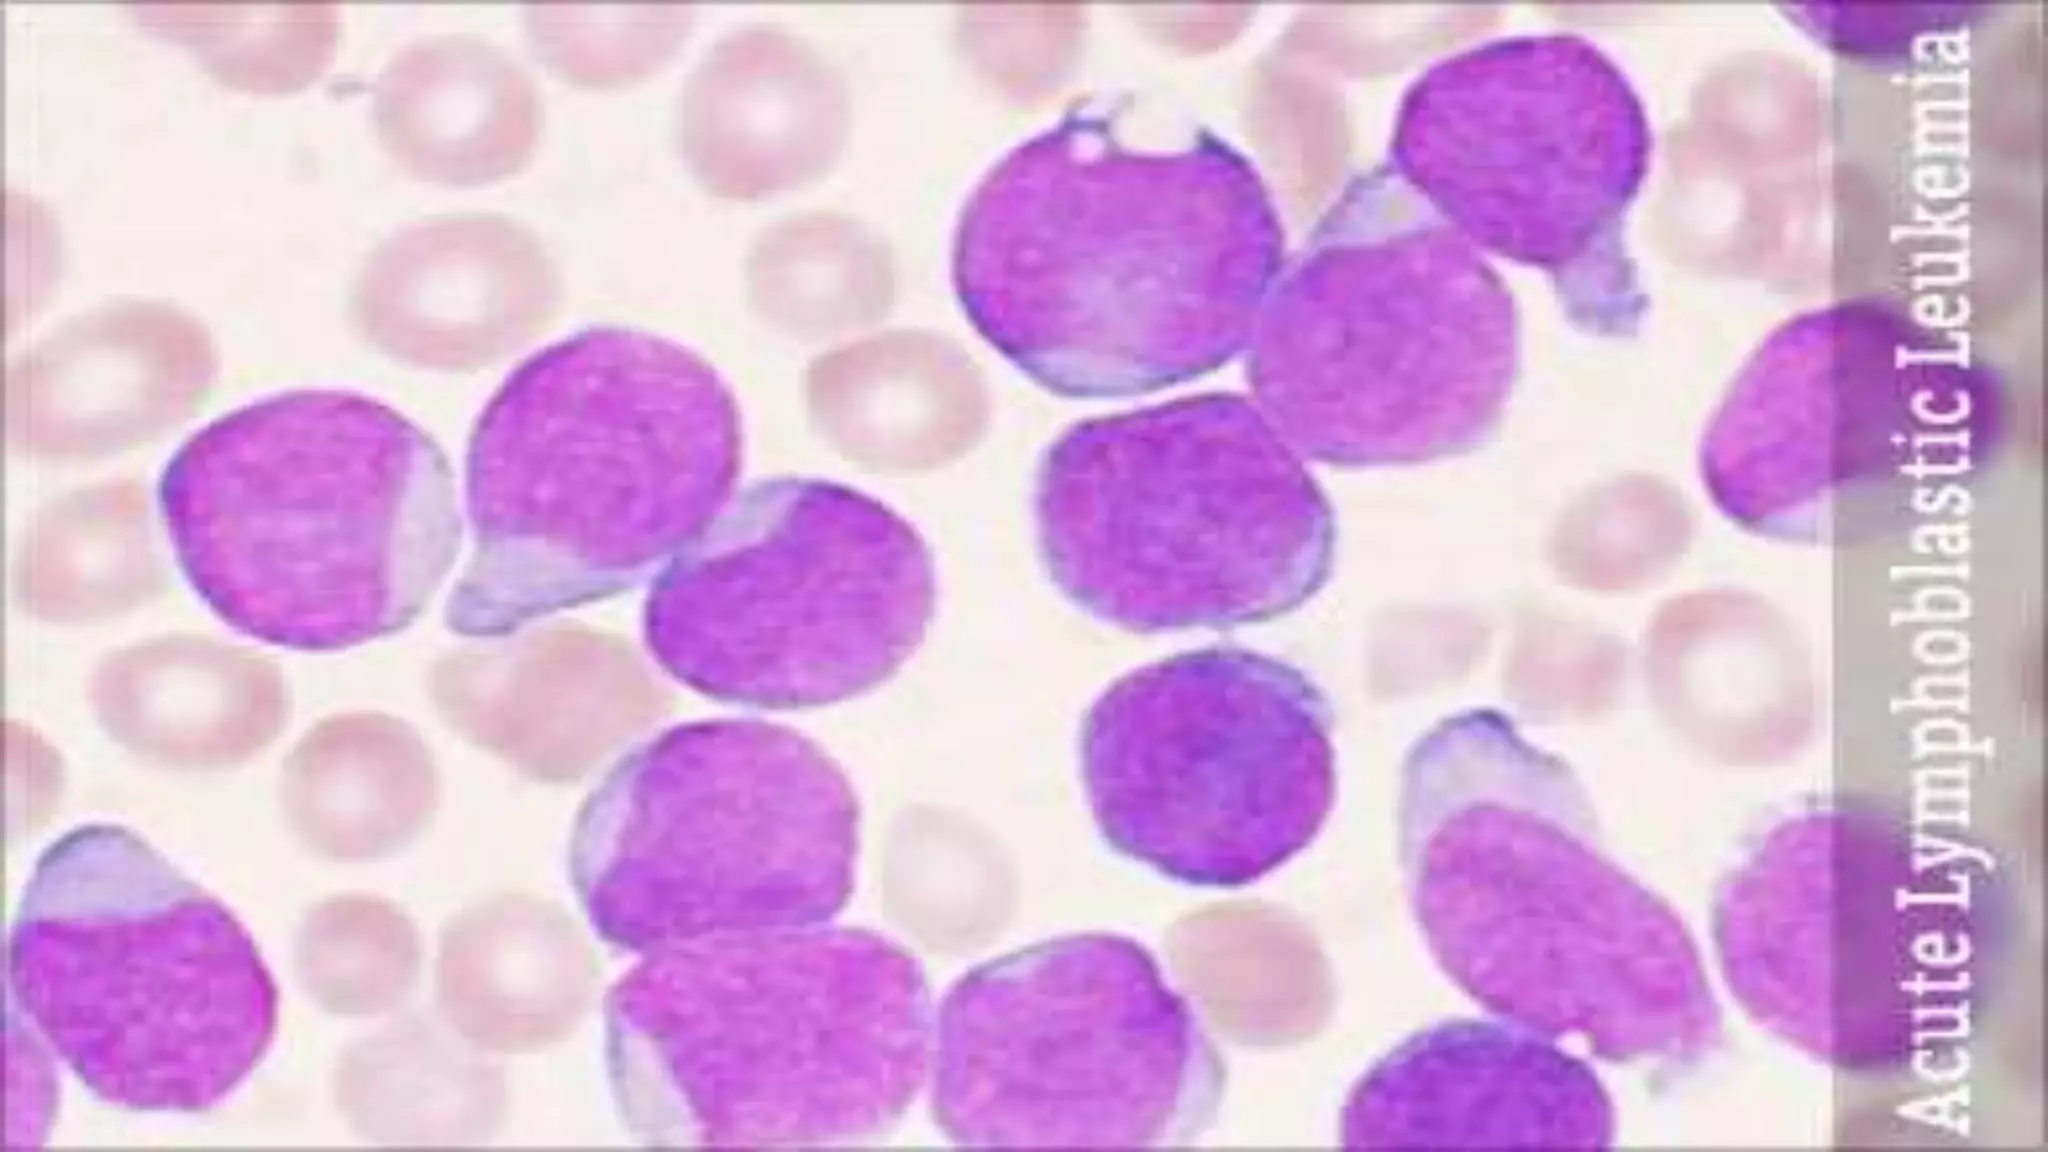
Myeloid neoplasm . Dr. Abhinav Golla , Associate Professor , Lab Director & Consultant Pathologist . Aadhya Medicure Pathlabs .

Embed presentation
Downloaded 12 times


















































































































White blood cells, also known as leukocytes, are immune cells that help the body fight infections and diseases. There are different types of white blood cells that perform various functions like fighting bacteria and viruses, producing antibodies, and more. Certain diseases can cause abnormalities in white blood cells, affecting the body's ability to fight infections and diseases.